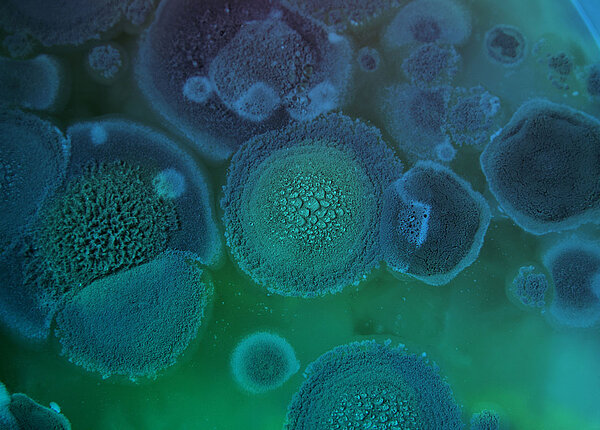
Resistenzen gegen andere Keime als Bakterien: So funktioniert die Resistenzbildung bei multiresistenten Erregern wie Pilzen, Viren und Parasiten. Aspergillus-fumigatus-Kultur in einer Petrischale: blau-grüner Pelz

Übergewicht/Zulassung
USA: NEUE MEDIKAMENTE ZUM ABNEHMEN
Seite 1/1 2 Minuten
Gerade für übergewichtige Menschen mit Diabetes sind diese Medikamente hilfreich, um abzunehmen und den Zuckerstoffwechsel zu verbessern. Die Deutsche Gesellschaft für Endokrinologie geht davon aus, dass diese Mittel auch in der Europäischen Union zugelassen werden. Die Wirkung der neuen Mittel sei aber begrenzt, und angesichts früherer Erfahrungen mit derartigen Medikamenten raten die Hormonexperten zu einer abwartenden Haltung.
In den letzten Jahrzehnten mussten immer wieder Appetitzügler wegen erheblicher Nebenwirkungen vom Markt genommen werden. Im Oktober 2008 entschied die Europäische Arzneimittelkommission, die Zulassung von Acomplia® (Wirkstoff: Rimonabant) ruhen zu lassen, da es schwere psychische Krisen bis hin zu Selbstmordgedanken auslösen kann. Reductil® (Wirkstoff: Sibutramin) wird wegen erheblicher Risiken für Herz und Kreislauf seit 2010 nicht mehr eingesetzt. In Deutschland ist derzeit nur noch Xenical® verfügbar. „Dessen Wirkstoff Orlistat hemmt die Fettverdauung im Darm und senkt dadurch die Kalorienzufuhr“, erläutert Professor Dr. med. Dr. h.c. Helmut Schatz, Mediensprecher der Deutschen Gesellschaft für Endokrinologie aus Bochum: „Das Mittel hat sich als sicher erwiesen, ist aber wegen seiner abführenden Wirkung nicht sehr beliebt.“
In den USA können Ärzte jetzt zwei neue Medikamente einsetzen. Ende Juni wurde Belviq® zugelassen, drei Wochen später folgte Qsymia® (Qnexa). Der Belviq®-Wirkstoff, ein Serotonin 2C-Rezeptor-Agonist, aktiviert im Gehirn Nervenzellen, die den Appetit hemmen. Als Nebenwirkungen können Kopfschmerzen, Übelkeit und Verstopfung auftreten. Qsymia® ist eine Kombination aus zwei bekannten Wirkstoffen, Phenteramin und Topiramat. „Bei diesen bereits seit längerer Zeit für andere Krankheitsbilder eingesetzten Medikamenten wurde als Nebenwirkung eine Gewichtsabnahme beobachtet“, berichtet Professor Schatz. Der Effekt ist allerdings begrenzt.
In den klinischen Studien erhielten die Teilnehmer Qsymia® diätunterstützend und nahmen etwa zehn Prozent des Körpergewichts ab. „Beide Wirkstoffe sind nur bei Fettleibigen zugelassen, deren Body-Mass-Index über 30 angestiegen ist“, erläutert Professor Schatz. „Diese Wirkstoffe sind keine Lifestyle-Medikamente, die eine schnelle Gewichtsabnahme ohne Diät ermöglichen“, mahnt er und weist auch auf die Risiken und Nebenwirkungen hin: Qsymia® beschleunigt den Herzschlag. Wenn es Frauen trotz strenger Kontraindikation während der Schwangerschaft einnehmen, besteht zudem für das ungeborene Kind ein Risiko, mit einer Lippen- oder Gaumenspalte zur Welt zu kommen. Belviq® (Lorcaserin) habe in Tierversuchen Krebs ausgelöst, was sich aber glücklicherweise in den klinischen Studien nicht bestätigte.
„Bei den ersten Medikamenten dieser Art, die jetzt nicht mehr erhältlich sind, traten die Risiken erst zutage, als diese schon längere Zeit auf dem Markt waren“, berichtet Professor Schatz: „Deshalb ist bei neuen Medikamenten zur Gewichtsreduktion Vorsicht geboten.“ Quelle: idw-online.de